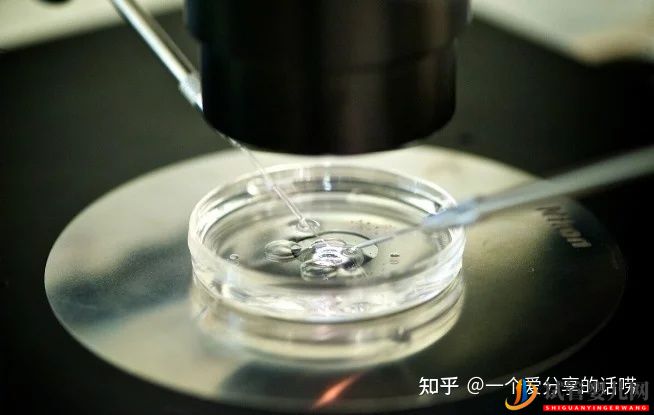
試管的時候,取卵痛嗎(圖2)

試管的時候,取卵痛嗎
(三代試管)試管嬰兒在目前是一項(xiàng)常見的生殖輔助受孕技術(shù),在操作的過程中主要將女性身體的卵子取出在體外和精子結(jié)合,形成受精卵后再放到女性宮腔內(nèi)著床發(fā)育,所以取卵是試管嬰兒過程中最重要的步驟之一。
一說到試管嬰兒,很多女性朋友肯定會問:取卵的時候會不會很痛?
那取卵的時候真的會痛嗎?

一般來講,在做取卵手術(shù)時所帶來的疼痛是可以忍受的,其實(shí)這種疼痛和女性的疼痛忍耐值有關(guān),也和她們的心理有關(guān)系。一些女性對疼痛的忍耐程度較低,在進(jìn)行時就會感覺特別痛苦,(三代試管)但是不用過于擔(dān)心,因?yàn)樵谌÷亚按蠖鄶?shù)醫(yī)生會采取一些止痛措施,如麻醉、口服止痛藥等,會讓女性根據(jù)自己對疼痛的忍受度而選擇止痛方法來降低帶來的疼痛。另外一般在取卵后大多數(shù)女性會有腹部疼痛墜脹感,這主要是因?yàn)樵谑中g(shù)時灌入二氧化碳使盆腔有少量積液導(dǎo)致,不用過于擔(dān)心。
取卵手術(shù)的過程到底是怎么樣的?
首先,取卵前醫(yī)生會對女性的陰道進(jìn)行消毒和沖洗,而且會讓女性排尿,膀胱處于排空狀態(tài)。
取卵時會用探針穿刺卵巢,再將B超探頭放入陰道內(nèi),借助探頭上的針(三代試管)管來吸取卵巢中的卵泡,在吸取成功后將卵泡放在試管內(nèi),將取出的卵泡放入玻璃器皿內(nèi)并且在顯微鏡下選擇出優(yōu)質(zhì)卵子取出,放在另外的器皿當(dāng)中等待成熟。
取卵后會有哪些情況?
女性在取卵后陰道會有少量出血,不用過于緊張,主要是因?yàn)榇┐剃幍缹?dǎo)致,一般在兩三天內(nèi)就會消失,又或者通過B超探頭下取卵會傷及血管導(dǎo)致出血現(xiàn)象,也不用過于焦慮,只要不會伴隨著其他不適就不用擔(dān)心。
不過要注意,在取卵后如果有發(fā)燒、陰道大量出血、腹部疼痛并且其他不適癥狀需及時就醫(yī),在醫(yī)生指導(dǎo)下進(jìn)行檢查采取措施,畢竟這些屬于取卵后的副作用,如果拖延只會帶來傷害。
溫情提示:
試管嬰兒在目前很常見,大多數(shù)不孕不育夫妻為了滿足自己擁有寶寶的愿望而選擇此項(xiàng)方法,而在操作的過程中取卵是一個必不可少的過程,因此女性對取卵過程可以做了解,并且對于取卵后會出現(xiàn)的癥狀有所掌握,才能在出現(xiàn)癥狀時不會驚慌失措。





